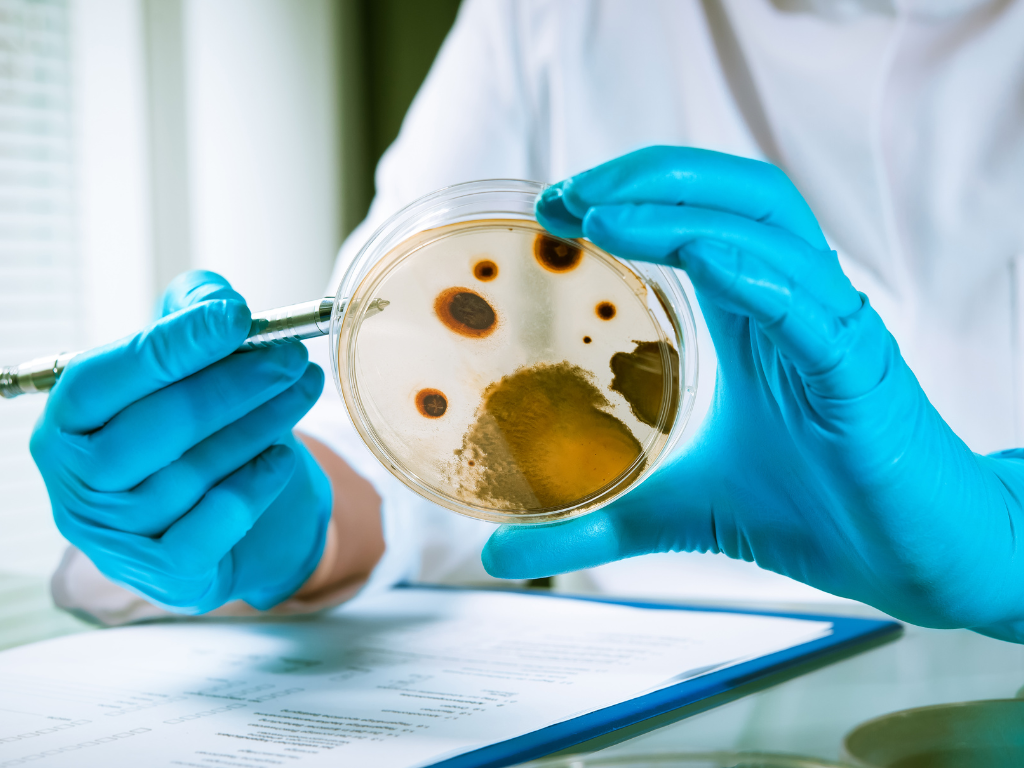

Veterinary Health Mark (VHM) is a certification scheme in Malaysia recognized by the Department of Veterinary Services (DVS). It serves as an assurance that livestock-based food products are processed in hygienic facilities and handled in a safe, controlled manner, fully compliant with veterinary public health requirements.
This certification incorporates key practices such as Hazard Analysis and Critical Control Points (HACCP), which helps businesses identify and manage food safety risks and Good Manufacturing Practices (GMP), which set guidelines for maintaining hygiene standards in production.
By obtaining VHM certification, businesses not only demonstrate their commitment to food safety but also build consumer trust and strengthen their market competitiveness.
Getting certified is a big step forward, but what’s the point if you don’t apply it? Check out our blog on “Top 3 Mistakes in HACCP Maintenance – #1: Learning Without Taking Action” to see why implementation matters most.

Meat Products

Dairy Products

Egg Manufacturing

Poultry Manufacturing

Product and Process Understanding

Prerequisite Programs (PRPs)

7 HACCP Principles
Validation and Verification
At Magcolm Solutions, we empower our clients to achieve lasting success through our professional advisory services and HRD Corp claimable courses.
We understand that implementing a new system or obtaining certification can be complex and many businesses lack the experience or time to start from scratch. That’s where we come in, providing valuable insights and hands-on support to help them reach their goals and navigate the process of obtaining various ISO and halal system certifications.
We work with committed clients who genuinely want to master the whole ISO certification process and take their business to the next level. When they are ready to take up the challenge and step up a gear in their business pursuit, so do we.
Joining forces to ensure a 100% success rate, every step of the way, in our journey towards a sustainable and long-term value creation.
Pack with project layout, SOPs and competency-based training in one complete solution to ensure 100% success!

Explore our Online Coaching Program, fully HRD Claimable! Start confidently with ready-to-use resources designed just for you.

Check out our E-Learning lessons, fully HRD Claimable! Start from scratch with a simple step-by-step guide.

Provide total solutions to synergize your system, products, processes and branding in one roof
Food industry experts with over 15+ years of hands-on experiences
Proven and Trusted. Grown with us, turning challenges into success stories
We bring energy, expertise and heart to every project, so your team leaves confident and capable
Get your VIP pass to our learning community with a free course on avoiding HRD Training Grant mistakes—your first step toward smarter learning, stronger connections, and bigger success.



Magcolm Solutions’ VHM consultant will assist your business in meeting the requirements of the Veterinary Health Mark (VHM) certification, a food safety assurance scheme regulated by the Department of Veterinary Services (DVS), Malaysia.
VHM certification ensures that meat, poultry and livestock-based food premises comply with hygiene, sanitation and veterinary inspection standards, allowing you to legally supply, process and distribute animal-based products locally and for export. Our VHM consultants provide end-to-end guidance, including:
We are food technologists by profession, approved VHM consultants and trainers recognized by the Malaysian Institute of Food Technologist (MIFT), HRD Corporation, Department of Veterinary Services (DVS) and Highfield International (UK).
With over 15 years of experience in the food safety industry, we’ve successfully assisted slaughterhouses, meat processors and cold chain facilities to achieve and maintain VHM certification, ensuring compliance with both DVS and import/export requirements.
100%. We believe success don’t just happen, it takes careful planning and dedication.
VHM certification proves your business operates under veterinary-supervised hygiene standards, giving assurance to consumers, regulators and trading partners that your products are safe, traceable and high-quality.

Meet Magcolm+! Find the right answers. Turn challenges into opportunities, together!